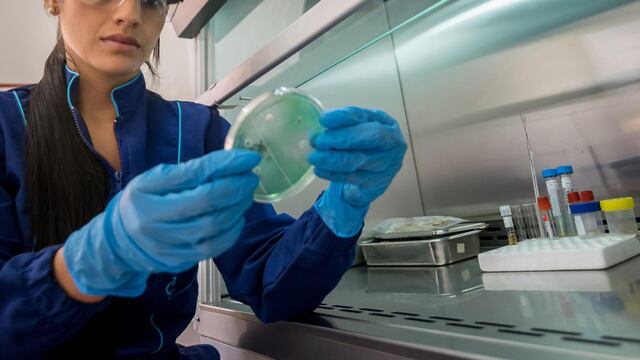

El Instituto de Seguridad Social del Estado de México y Municipios (ISSEMYM) renovará el servicio de laboratorio clínico en 22 hospitales con tecnología actualizada.
El contrato fue adjudicado a Instrumentos y Equipos Falcón y Arquina, garantizando mejores condiciones para los pacientes.
El acuerdo del ISSEMYM entrará en vigor el 1 de mayo y finalizará el 21 de diciembre de 2025.




Se aplicará bajo la modalidad de contrato abierto con pago por prueba y préstamo de equipo, permitiendo mayor precisión en los resultados y optimización en los tiempos de respuesta.
Empresas seleccionadas por ISSEMYM
Las compañías ganadoras cumplieron con los requisitos establecidos, informó el ISSEMYM.
Instrumentos y Equipos Falcón, con más de 45 años de experiencia en el sector salud, fortalecerá la confiabilidad en los servicios.
En contraste, Centrum Promotora Internacional fue descalificada por falta de documentación y registros sanitarios vigentes.
ISSEMYM avanza en la modernización de su infraestructura
Con este contrato, el ISSEMYM avanza en la modernización de su infraestructura de salud, mejorando la eficiencia en la atención hospitalaria.
Asimismo, con esto eleva la calidad de los servicios de salud en el Estado de México.